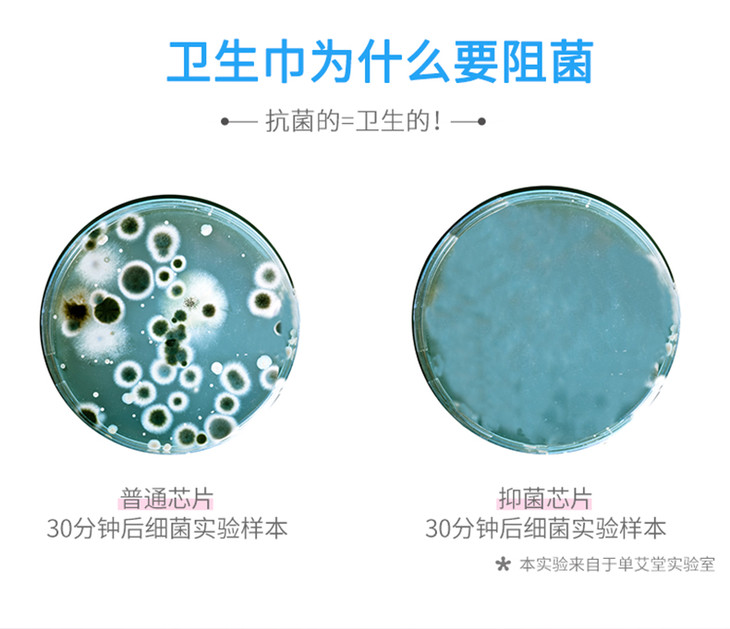

以艾为爱 竹纤维艾草卫生巾日用 10片装(2026年8月到期)
¥19.90 - 99.50
中秋国庆
原价:¥29.90 - 149.50
| 运费: | ¥ 7.00-999.00 |
| 库存: | 3667 件 |
商品详情

- 单艾堂艾生活商城 (微信公众号认证)
- 单桂敏老师从医四十余年,为弘扬中医传统艾灸等绿色疗法,联合贾晓洁女士共同创立了单艾堂,以“艾”为爱,温暖生命,是单艾堂的服务宗旨!
- 扫描二维码,访问我们的微信店铺
- 随时随地的购物、客服咨询、查询订单和物流...